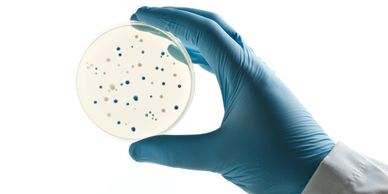

OUR SCIENCE
Target Consumer Product Identification
Application Specific Strain Identification and Characterization
Application Specific Strain Identification and Characterization

We begin by working with you to clearly define the target consumer product and its intended benefits. This crucial first step ensures our microbial solution is a perfect fit for your market.
Application Specific Strain Identification and Characterization
Application Specific Strain Identification and Characterization
Application Specific Strain Identification and Characterization
We partner with you to identify the optimal probiotic strains, meticulously matching their functional traits to your specific product requirements.
Upstream and Downstream Optimization
Application Specific Strain Identification and Characterization
Upstream and Downstream Optimization

We employ advanced fermentation strategies to simultaneously increase biomass density and metabolite titers while enhancing nutrient utilization for a more efficient process and improved cost effectiveness.
Pre pilot scale strain development
Product Specific Bioactivity Optimization
Upstream and Downstream Optimization

Our R&D team executes the complete pre-pilot prototype pipeline, including isolation, characterization, scale-up feasibility, and product performance testing.
Formulation and Formats
Product Specific Bioactivity Optimization
Product Specific Bioactivity Optimization

We optimize the post-processing of our probiotic ingredients to ensure they are compatible with your specific product packaging requirements. This includes techniques that maintain strain viability and efficacy throughout the product's shelf life.
Product Specific Bioactivity Optimization
Product Specific Bioactivity Optimization
Product Specific Bioactivity Optimization

We fine-tune the biomass-to-bioactivity ratio through controlled optimization, ensuring it is customized to product-specific needs.
Scaling for Commercialization
Shelf Life Stability and Field Trials
Shelf Life Stability and Field Trials

We seamlessly scale the manufacturing process from pilot to commercial scale, guaranteeing consistent quality and performance for large-volume production.
Shelf Life Stability and Field Trials
Shelf Life Stability and Field Trials
Shelf Life Stability and Field Trials

Our formulations are engineered for robust shelf life with proven viability retention, supported by stability testing and real-world field trials. In addition to delivering high-quality probiotic ingredients, we offer end-to-end technical expertise and scientifically validated data, ensuring your product is market-ready and trusted by customers.
Regulatory Compliance
Shelf Life Stability and Field Trials
Continuous Improvement of Strain and Process

All our processes adhere to regulatory standards, with stringent controls applied both internally and in verification and validation of the finished product.
Continuous Improvement of Strain and Process
Continuous Improvement of Strain and Process
Continuous Improvement of Strain and Process
Through daily data-driven insights, we refine strains, optimize processes, and achieve superior performance benchmarks, enabling both technical efficiency and cost optimization.
Jinsei Bioscience Pvt. Ltd.
Ncl innovation park, dr. homi bhabha rd, pashan colony, pashan, pune 411008
Copyright © 2025 Jinsei Bio - All Rights Reserved.
Contact us at info@jinseibio.com
This website uses cookies.
We use cookies to analyze website traffic and optimize your website experience. By accepting our use of cookies, your data will be aggregated with all other user data.